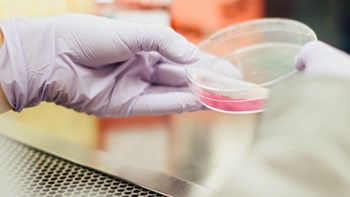
Κορονοϊός: Ένα νέου τύπου γρήγορο τεστ ανίχνευσης προτείνουν Έλληνες ερευνητές

Μια διεπιστημονική ομάδα ερευνητών του ΕΚΕΦΕ «Δημόκριτος» προτείνει μια νέα λύση για τη γρήγορη ανίχνευση του κορονοϊού SARS-CoV-2, με βάση μια ήδη υπάρχουσα τεχνολογία που θα μπορούσε να αξιοποιηθεί στην περίπτωση της Covid-19. Η σχετική ιδέα συμμετείχε στον διαγωνισμό EUvsVirus Hackathon, που διοργανώθηκε από την Ευρωπαϊκή Επιτροπή και το Ευρωπαϊκό Συμβούλιο Καινοτομίας, στο τέλος Απριλίου και ήταν μια από αυτές που διακρίθηκε. Ήδη, οι λύσεις που αναδείχθηκαν νικητές προωθούνται από το Ευρωπαϊκό Συμβούλιο Καινοτομίας για αξιοποίηση και θα προσκληθούν να συμμετάσχουν στην νέα ευρωπαϊκή πλατφόρμα COVID, η οποία θα λειτουργήσει από το τέλος Μαΐου με στόχο να διευκολύνει τις διασυνδέσεις με τους τελικούς χρήστες, όπως τα νοσοκομεία, δίνοντας παράλληλα πρόσβαση σε επενδυτές, ιδρύματα και άλλους φορείς από όλη την ΕΕ που παρέχουν ευκαιρίες χρηματοδότησης. Η πρόταση του «Δημόκριτου» έχει τίτλο “Υποστρώματα SERS για την ανίχνευση του κορονοϊού σε εκπνεόμενα σωματίδια” και υποβλήθηκε στην κατηγορία “Γρήγορα τεστ χαμηλού κόστους”. Βασίζεται σε μια οπτική τεχνική ανίχνευσης μορίων -όπως πρωτεϊνών του ιού- με τη χρήση λέιζερ, που ονομάζεται SERS (Surface Enhanced Raman Scattering) και η οποία υλοποιείται ακόμα και με συσκευές χειρός, έχοντας ήδη ευρεία εφαρμογή, όπως π.χ. στην ανίχνευση ναρκωτικών στα αεροδρόμια.Η καινοτόμος ιδέα αφορά στην προσαρμογή της τεχνικής για την ανίχνευση του κορονοϊού και τη συλλογή του σε φίλτρα αέρα, κατάλληλα τροποποιημένα με νανοσωματίδια. Η μέθοδος SERS είναι εξαιρετικά ευαίσθητη και δίνει αποτελέσματα σε μερικά λεπτά, σύμφωνα με τους Έλληνες ερευνητές, οι οποίοι ευελπιστούν ότι αν γίνει δυνατή η αξιοποίηση της, τότε θα είναι ιδιαίτερα χρήσιμη σε νοσοκομεία, σχολεία, αεροδρόμια και άλλους χώρους μαζικής συνεύρεσης πληθυσμού.
ΠΗΓΗ: ΑΠΕ